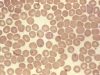
Бабезиоз впервые зафиксирован в Молдове

Сейчас В Тренде
POPULAR NEWS
Вячеслав Платон: «Усатый работал на Плахотнюка против социалистов» (ВИДЕО)
Sorry, this entry is only available in Русский. For the sake of viewer convenience, the content is shown below in the alternative language. You...
РАЗБОР ПОЛЕТОВ: ЛЮДИ, КОГДА ВЫ, НАКОНЕЦ-ТО БУДЕТЕ ОСТОРОЖНЫ?!
Sorry, this entry is only available in Русский. For the sake of viewer convenience, the content is shown below in the alternative language. You...
WRC RACING WORLD
[td_block_social_counter custom_title=”STAY CONNECTED” border_top=”no_border_top” facebook=”tagdiv” twitter=”tagdivofficial” youtube=”tagdiv”]
FOOTBAL
HORSE RACING
САМЫЕ ПОСЛЕДНИЕ СТАТЬИ
В Молдове ужесточают правила охраны труда
Sorry, this entry is only available in Русский. For the sake of viewer convenience, the content is shown below in the alternative language. You...
Христиане отмечают праздник Введения во храм Пресвятой Богородицы
Sorry, this entry is only available in Русский. For the sake of viewer convenience, the content is shown below in the alternative language. You...
Наркорынок Молдовы: почти половина управляется из ЕС
Sorry, this entry is only available in Русский. For the sake of viewer convenience, the content is shown below in the alternative language. You...
Каждый восьмой подросток к 18 годам сталкивается с нарушениями слуха
Sorry, this entry is only available in Русский. For the sake of viewer convenience, the content is shown below in the alternative language. You...
Собаки чувствуют стресс человека по запаху
Sorry, this entry is only available in Русский. For the sake of viewer convenience, the content is shown below in the alternative language. You...
Молдавские игристые вина признаны одними из лучших в мире
Sorry, this entry is only available in Русский. For the sake of viewer convenience, the content is shown below in the alternative language. You...
В Молдове прогнозируют самый низкий рост зарплат за пять лет
Sorry, this entry is only available in Русский. For the sake of viewer convenience, the content is shown below in the alternative language. You...
Декабрь в Молдове будет теплее обычного
Sorry, this entry is only available in Русский. For the sake of viewer convenience, the content is shown below in the alternative language. You...
ANSA изъяла 5 тонн опасного пальмового масла
Sorry, this entry is only available in Русский. For the sake of viewer convenience, the content is shown below in the alternative language. You...
В Молдове зафиксировано почти 900 новых случаев ВИЧ
Sorry, this entry is only available in Русский. For the sake of viewer convenience, the content is shown below in the alternative language. You...

Русский
Română